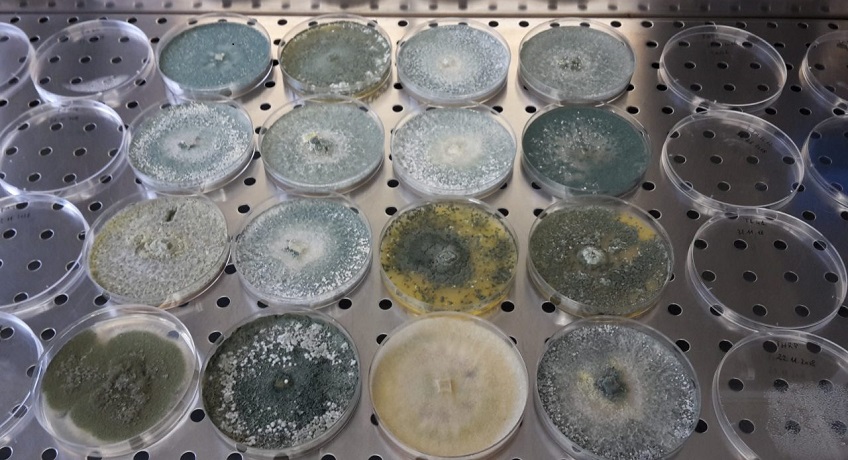

Indice
- Qual è il ruolo dei microrganismi del suolo? In che modo favoriscono la sostenibilità? Essi sono indispensabili per:
- rendere disponibili i minerali assorbiti dalle radici,
- stimolare la crescita delle colture e
- proteggerle dalle malattie.
- I microrganismi, principalmente batteri e funghi, sono importantissimi in tutti gli ecosistemi, poiché il loro lavoro è necessario per rendere disponibili gli elementi nutritivi fondamentali per le piante, come ad esempio l’azoto, il carbonio e il fosforo, in quanto tali elementi sono componenti essenziali di proteine, grassi, zuccheri, DNA e altre molecole complesse, che compongono la materia vivente.
- Il Fosforo
- Batteri
- Produzione di fitormoni
- Alcuni microrganismi detti “antagonisti”, posseggono proprietà tali da poter essere utilizzati per attuare la cosiddetta “lotta biologica” ai patogeni delle piante (insetti, funghi, batteri).
- Biofungicidi
- Antagonismi microbici fungini
- Alcuni microrganismi antagonisti sono molto specifici.
- La ricerca in questo ambito cerca di incrementare l’efficacia degli antagonisti microbici ampliando anche il loro “spettro d’azione”, cioè la loro capacità di agire contro patogeni diversi.
Qual è il ruolo dei microrganismi del suolo? In che modo favoriscono la sostenibilità? Essi sono indispensabili per:
-
rendere disponibili i minerali assorbiti dalle radici,
-
stimolare la crescita delle colture e
-
proteggerle dalle malattie.
I microrganismi sono imprescindibili per tutti i settori del primario, dall’orticoltura alla frutticoltura, dal florovivaismo alla produzione dei foraggi, per aumentare i livelli di sostenibilità delle filiere assicurando la qualità con protocolli di gestione sempre più “green”.
Scopriamo le innovazioni che la ricerca di settore rende continuamente disponibili.
I microrganismi che vivono nel suolo svolgono un ruolo cruciale nel permettere agli agricoltori di realizzare produzioni agricole sostenibili per l’ambiente. Molti di essi sono, infatti, indispensabili per:
- rendere disponibili alle piante elementi minerali assorbiti dalle radici,
- stimolare la crescita delle colture e
- proteggere queste ultime dalle malattie che, spesso, causano importanti perdite di produzione, se non si interviene tempestivamente con sostanze chimiche generalmente impattanti per la salute dell’uomo e dell’ambiente.

Sospensione di suolo osservata al microscopio ottico in cui si evidenziano alcuni funghi che appaiono come filamenti bruni (ife). Foto di Paola Iovieno, ricercatrice CREA Orticoltura e Florovivaismo
I microrganismi, principalmente batteri e funghi, sono importantissimi in tutti gli ecosistemi, poiché il loro lavoro è necessario per rendere disponibili gli elementi nutritivi fondamentali per le piante, come ad esempio l’azoto, il carbonio e il fosforo, in quanto tali elementi sono componenti essenziali di proteine, grassi, zuccheri, DNA e altre molecole complesse, che compongono la materia vivente.
L’azoto è il principale elemento nutritivo fondamentale per la crescita delle piante; è il principale componente dell’aria (ben 78%) ed è direttamente utilizzabile solo da particolari microrganismi denominati, per l’appunto, azotofissatori, in quanto capaci di assorbire e trasformare l’azoto atmosferico in un composto (l’ammonio) che le piante possono utilizzare per sintetizzare molecole complesse fondamentali, quali le proteine e il DNA. Alcuni microrganismi azotofissatori vivono liberi nel terreno, mentre altri vivono in simbiosi con le radici delle leguminose (per intenderci fagioli, ceci, piselli, lenticchie e legumi in genere) formando sulle radici stesse delle caratteristiche escrescenze, visibilissime ad occhio nudo, denominate “tubercoli radicali”. E’ in questi tubercoli che vivono e “lavorano” questi microrganismi azotofissatori simbionti. L’azoto può essere anche liberato a seguito della decomposizione della sostanza organica, giunta al suolo come residuo agricolo o come letame o compost. I microrganismi che liberano tale azoto lo trasformano ancora una volta in ammonio direttamente assorbito dalle radici delle piante.

Radice di fagiolino micorrizata, colorata con blu di anilina in acido lattico, osservata al microscopio ottico. La freccia indica un arbuscolo, struttura tipica delle endomicorrize. Foto di Paola Iovieno, ricercatrice CREA Orticoltura e Florovivaismo
Il Fosforo
Il fosforo è spesso presente nel terreno in forme chimiche difficilmente assimilabili dalle piante. Alcune specie di funghi vivono in simbiosi con le radici formando le cosiddette “micorrize” (cioè fungo + radice), che sono in grado di assorbire maggiormente il fosforo dal terreno e metterlo a disposizione delle piante. Inoltre, favoriscono anche l’assorbimento di azoto, microelementi e acqua. In genere la micorrizazione delle piante avviene spontaneamente in natura, ma può essere anche favorita mediante l’inoculazione di preparati commerciali contenenti spore di funghi micorrizici. Alcuni batteri e funghi che vivono nel suolo liberano il fosforo dalla sostanza organica, rendendolo pertanto assimilabile dalle piante.
La maggior parte dei microrganismi, in presenza di ossigeno, è capace di degradare gli zuccheri e molecole più complesse (es. cellulosa, lignina, ecc.), formate per la maggior parte da carbonio, fino ad arrivare alla produzione di molecole molto semplici, cioè anidride carbonica ed acqua.
Le sostanze più resistenti alla decomposizione vanno incontro a processi chimici di sintesi che determinano la formazione di humus, sostanza complessa da cui dipende direttamente la qualità e la produttività del suolo. Importante è anche il ruolo dei microrganismi “decompositori” nella trasformazione in compost dei rifiuti organici prodotti dall’uomo (ad esempio “l’umido” della raccolta differenziata).
Batteri
Nel suolo, in prossimità delle radici o strettamente associati ad esse vi sono anche batteri capaci di promuovere la crescita delle piante (in inglese “plant growth promoting rhizobacteria”, acronimo PGPR). I meccanismi attraverso i quali i PGPR sono in grado di promuovere la crescita dei vegetali sono diversi: fissazione dell’azoto atmosferico, solubilizzazione del fosforo, produzione di fitormoni. Della fissazione dell’azoto ne abbiamo parlato in precedenza. Possiamo solo aggiungere che i microrganismi capaci di “fissare” l’azoto atmosferico vengono definiti “biofertilizzanti”, in quanto forniscono azoto alle piante, fertilizzante che non può mai mancare in agricoltura. Anche della solubilizzazione del fosforo si è fatto in precedenza cenno parlando delle micorrize. Bisogna comunque sapere che, oltre alle micorrize, esistono batteri capaci di solubilizzare il fosforo minerale insolubile presente nel suolo, consentendo pertanto alle piante di assorbirlo attraverso le radici.
Produzione di fitormoni
Riguardo la produzione di fitormoni, questo meccanismo consiste nella produzione, da parte di alcuni microrganismi, di sostanze ad azione ormonale (es. auxine, gibberelline e citochinine) capaci di stimolare lo sviluppo delle radici e della parte aerea delle piante. Alcuni microrganismi sono anche capaci di degradare ormoni vegetali, quali l’etilene, che inibiscono la crescita delle piante. I microrganismi capaci di produrre fitormoni stimolanti o capaci di degradare fitormoni inibitori della crescita, vengono definiti “fitostimolanti”.
Alcuni microrganismi detti “antagonisti”, posseggono proprietà tali da poter essere utilizzati per attuare la cosiddetta “lotta biologica” ai patogeni delle piante (insetti, funghi, batteri).
Contribuiscono così alla riduzione dell’impiego dei fungicidi di sintesi nella produzione di ortaggi, frutta e verdura e mitigano “l’impronta ecologica” del settore primario.
Queste proprietà sono legate a particolari meccanismi quali:
- secrezione di antibiotici,
- sottrazione di elementi nutritivi essenziali alla crescita (per es. elementi come ferro e carbonio),
- occupazione fisica dell’ambiente,
- parassitizzazione o predazione del microrganismo dannoso per le piante e/o
- conferimento alle piante di una maggiore vitalità e capacità di resistere agli attacchi futuri dei patogeni (meccanismo quest’ultimo noto come “resistenza sistemica indotta”).
Biofungicidi
Tali antagonisti microbici vengono selezionati, moltiplicati e confezionati dall’uomo per essere impiegati in agricoltura come “biofungicidi”. Tutti i settori della produzione primaria – dall’orticoltura alla frutticoltura, dal florovivaismo alla produzione dei foraggi – per aumentare i livelli di sostenibilità delle filiere ed accedere a regimi di qualità con protocolli di gestione sempre più ecosostenibili, non possono fare a meno delle innovazioni che la ricerca di settore rende continuamente disponibili.
Antagonismi microbici fungini
Tra gli antagonisti microbici più largamente commercializzati a livello mondiale si annoverano diverse specie fungine (per es. quelle del genere Trichoderma) e batteriche (come per es. Bacillus e Pseudomonas) che fondano la gran parte del loro successo sulla:
- spiccata capacità di adattamento alle diverse condizioni ambientali,
- possibilità di essere distribuiti in confezioni ad hoc e conservati per un congruo periodo di tempo.
Alcuni microrganismi antagonisti sono molto specifici.
Ad esempio, il fungo antagonista denominato Coniothirium minitans è un parassita specifico di patogeni che vivono nel suolo e che causano marciumi alla base di piantine allevate in vivaio; il Pythium oligandrum è un oomicete (un particolare tipo di fungo) parassita di altri oomiceti che causano malattie delle piante note con il nome di peronospora (per es. Phytophthora spp.).
Il fungo Ampelomyces quisqualis è un antagonista agente di biocontrollo largamente impiegato nella difesa delle colture dal “mal bianco o oidio”, una malattia che si manifesta con formazioni bianche polverulenti sulle superfice delle foglie.
La ricerca in questo ambito cerca di incrementare l’efficacia degli antagonisti microbici ampliando anche il loro “spettro d’azione”, cioè la loro capacità di agire contro patogeni diversi.
A tal riguardo, viene sperimentata la somministrazione dei microrganismi antagonisti insieme ad ammendanti organici ad azione probiotica e/o l’impiego di più combinazioni di microrganismi (che prendono il nome di “consorzi microbici”), in modo da aumentare la capacità di adattamento ad ambienti diversi e aumentare il range di patogeni da controllare.
Fonte: www.creafuturo